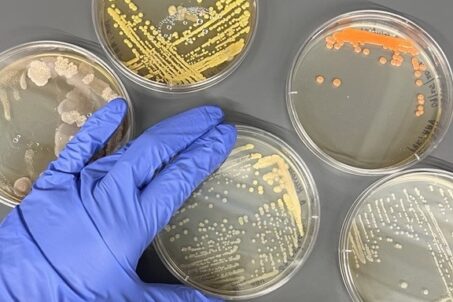

In this Microbiology workshop, participants will be introduced to the basic skills needed to work with Risk Group 1 microorganisms in the WLM. You will learn how to acquire, store, and cultivate microbes, pour plates, dispose of biological waste, and become familiar with some common tools used for microbiology projects.
Familiarity with using a micropipette is required. If you are unfamiliar with this instrument, we suggest you take our Basic Lab Skills Workshop. This training does NOT provide access to our BSL2 microbiology space.
Maximum attendance for this workshop is 6. Pre-registration is not mandatory, but to ensure a space is available, please sign up below.